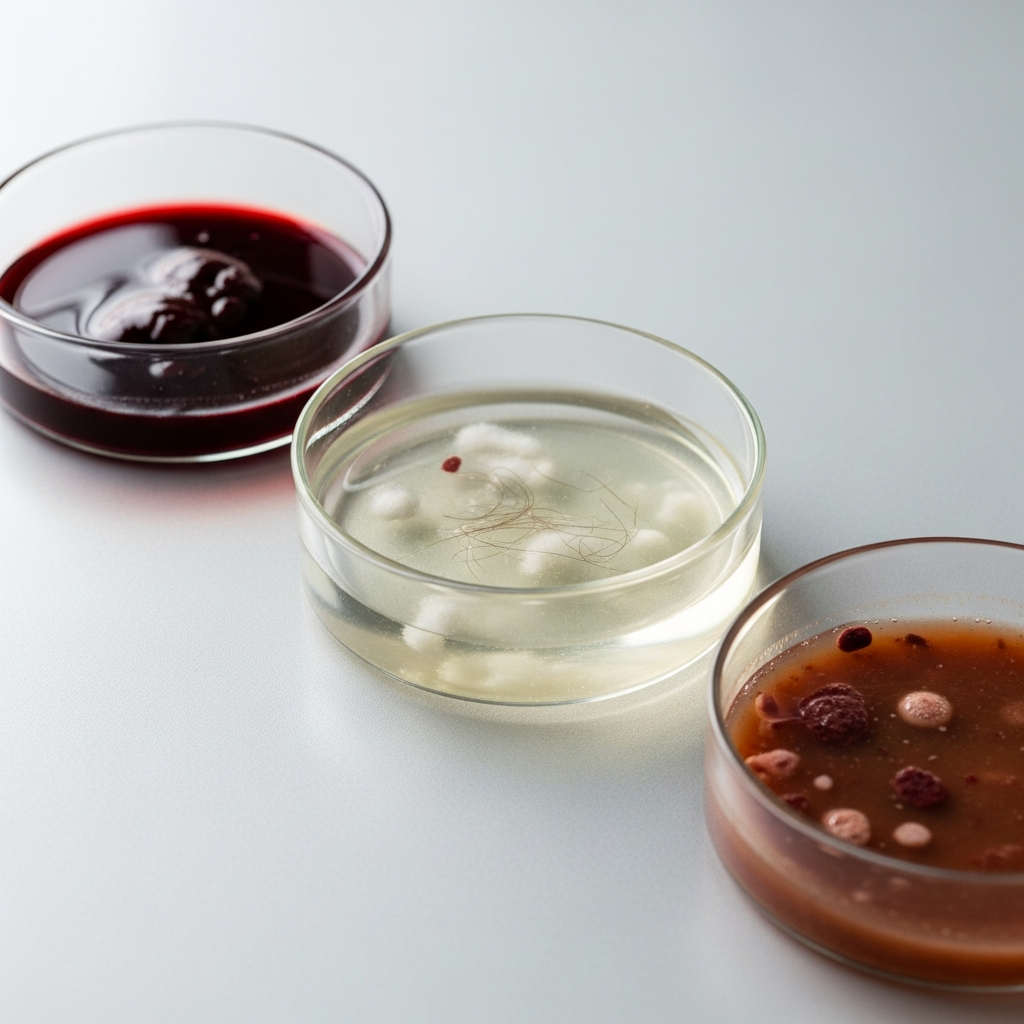

Bringing a new life into the world is an incredibly profound and beautiful experience. It’s filled with anticipation, joy, and that undeniable first glance at your precious baby. We often hear about the wonder, the miracle, and the overwhelming love that fills the delivery room. And all of that is absolutely true and amazing!
But let’s be real for a moment. Childbirth, at its core, is also a very intense physical process. Your body is doing something extraordinary, and sometimes, extraordinary can be a little… messy. There are certain things that often get left out of the glowing birth stories and gentle prenatal classes. They’re not pretty, they might even sound a bit gross, but they are completely normal parts of the journey.
Knowing about these less-talked-about realities beforehand can actually be empowering. It helps you prepare, reduces surprises, and lets you focus on the main event: meeting your baby. So, let’s pull back the curtain on some of the not-so-glamorous, but totally normal, things that can happen when you give birth.
1. The Unexpected Poop Show
This is probably one of the most common “gross” things parents-to-be worry about, and for good reason. It’s not exactly something you picture when you dream of your birth day. But here’s the scoop: it happens, and it’s completely normal.
What Happens
During labor, especially in the pushing phase, your body is working incredibly hard. The muscles you use to push your baby out are the same ones you use to have a bowel movement. Plus, your baby’s head is pressing down on your rectum, which can add to the sensation and the likelihood of a little accidental release.
It’s often just a small amount, but the important thing to remember is that it’s simply a sign that you’re pushing effectively.
Why It’s Normal
Your medical team has seen it all, hundreds, if not thousands of times. They are completely unfazed by it. Their focus is solely on you and your baby’s safe arrival. A nurse will quietly clean it up, and you’ll likely barely even notice it happened.
How to Cope
Don’t let the fear of pooping hold you back from pushing with all your might. Holding back can prolong labor and make it harder for your baby to descend. Trust your body, listen to your care team, and know that this is a natural part of the process. Seriously, no one is judging you.
2. Nausea and Vomiting Aren’t Just for Morning Sickness
You might think once you’re past the first trimester, you’re done with the queasy stomach. Think again! Nausea and vomiting can make an unwelcome return during labor and even after delivery.
During Labor
There are several reasons why you might feel sick during labor. The intense pain contractions can bring sometimes makes people feel nauseous. Certain medications, like epidurals or pain relief, can also have vomiting as a side effect.
Sometimes it’s simply your body’s extreme reaction to the immense effort and stress of childbirth.
Post-Delivery Chills
Right after your baby is born, many women experience intense shivering or a feeling of being very cold, even if the room is warm. This can sometimes be accompanied by a wave of nausea.
This is often due to a sudden shift in hormones and fluids in your body, as well as the adrenaline rush wearing off.
What to Expect
If you feel nauseous, let your nurse know. They can provide you with a basin, offer small sips of water or ice chips, and sometimes even give you medication to help settle your stomach. Don’t be embarrassed; it’s a common response to the stress and changes your body is going through. It usually passes once your baby is out and your body starts to recover.
3. An Ocean of Fluids: Blood, Amniotic Fluid, and Lochia
Childbirth is a wonderfully wet and messy event. Your body is full of fluids that will make their exit at various stages of the process, and it’s often much more than you might imagine.
Breaking Water
For some women, their “water breaking” is a dramatic gush, like in the movies. For others, it’s more of a slow trickle. Either way, once your amniotic sac ruptures, you’ll be continually leaking fluid until your baby is born.
Amniotic fluid is usually clear or pale yellow, and it doesn’t stop. You’ll likely wear large pads or be on absorbent mats to manage it.
Blood During and After Birth
There will be blood. A lot of it. During the delivery, and especially after the baby is born and the placenta is delivered, it’s normal to lose a fair amount of blood. Your care team will monitor this closely.
Then, for several weeks postpartum, you will experience something called lochia. This is your body’s way of shedding the lining of your uterus that grew during pregnancy. It starts out looking like a very heavy period, bright red with clots, and gradually fades to pinkish, then brownish, and finally yellowish-white over weeks.
The Placenta’s Exit
After your baby arrives, there’s still one more “delivery” – the placenta. This organ, which nourished your baby for months, also brings more fluids and blood as it detaches from your uterus. It’s all part of the natural process of your body returning to its non-pregnant state.
4. Delivering the Placenta: The Afterbirth Reveal
Everyone focuses on the baby’s arrival, but few talk about the “afterbirth” – the placenta. This is an incredible organ that has done an amazing job supporting your baby, but its exit can also be a bit… surprising.
What It Is
The placenta is a temporary organ that develops in your uterus during pregnancy. It provides oxygen and nutrients to your growing baby and removes waste products from your baby’s blood. It’s truly a life-sustaining powerhouse.
What It Looks Like
Once it’s delivered, the placenta looks much different than you might expect. It’s typically a disc-shaped organ, about the size of a dinner plate, thick and spongy, with a dark reddish-purple color. You’ll see the umbilical cord attached to it, branching out into a network of blood vessels.
Some parents ask to see it, while others prefer not to. Both choices are completely fine.
The Process
After your baby is born, you’ll usually have a few more contractions to push out the placenta. This part is generally much easier and less painful than delivering the baby. Sometimes, your doctor or midwife may gently pull on the umbilical cord to help it along.
In some cases, if the placenta doesn’t come out on its own, your doctor might need to manually remove it. This is done carefully and can be a bit uncomfortable, but it’s important to ensure your uterus is completely empty.
Why It’s Important
Ensuring the entire placenta is delivered is crucial for your health. Any leftover fragments can cause bleeding or infection, so your care provider will carefully inspect it to make sure it’s intact. This quick check helps prevent potential complications for you.
5. The Uncontrollable Post-Birth Shakes
You’ve just gone through an incredible ordeal, your baby is in your arms, and you’re filled with emotion. Then, out of nowhere, you start shaking uncontrollably. Your teeth might chatter, and you might feel a sudden chill, even if the room temperature is comfortable.
What They Are
These are often called “post-birth tremors” or “postpartum chills.” They can range from a slight shiver to full-body shakes that make it hard to hold your baby steady. It’s important to know that you are not cold, even if it feels like it.
Why They Happen
There isn’t one single reason for these shakes, but several factors contribute. It’s often linked to the massive hormonal shifts happening in your body after delivery, the adrenaline rush of birth, and the sudden drop in blood pressure that can occur. If you had an epidural, it can also be a side effect.
How to Deal
The shakes are a normal, albeit weird, physiological response. They are temporary and usually subside within an hour or so. Nurses will often offer warm blankets to help you feel more comfortable. Just try to relax into it, focus on your baby, and know that it will pass. It’s just your body’s way of processing everything it’s just been through.
6. Peeing Yourself (or Feeling Like It)
During and after childbirth, your bladder goes through a lot. The pressure, the exhaustion, and the changes to your pelvic floor muscles can lead to some moments where you might lose control of your bladder.
During Labor
With a baby pressing down on your bladder and the intense focus required for pushing, it’s not uncommon to accidentally leak a little urine during labor. If you have an epidural, you might not even feel the urge to pee, which means your bladder can get very full.
Because of this, nurses often insert a catheter to drain your bladder periodically, or keep it in place for a short time, to prevent it from getting too full and interfering with the baby’s descent.
After Birth
In the days and even weeks following childbirth, many women experience temporary urinary incontinence. Your pelvic floor muscles, which support your bladder, uterus, and bowels, have been stretched and possibly weakened. Swelling from the birth can also temporarily affect nerve function.
You might find that coughing, sneezing, laughing, or lifting your baby causes a little leakage. It can feel disheartening, but it’s a very common postpartum issue.
Recovery Tips
This situation usually improves significantly with time and consistent effort. Start doing pelvic floor exercises, often called Kegels, as soon as you feel comfortable after birth. These exercises help strengthen the muscles that support your bladder.
For immediate comfort, postpartum pads or adult diapers will become your new best friend for a while. Don’t be afraid to wear them – they’re a practical solution for a temporary problem. If issues persist, talk to your doctor; they might recommend a pelvic floor physiotherapist who can provide tailored exercises and guidance.
Embracing the Messy Miracle
Childbirth is truly a messy miracle, and embracing all aspects of it can help you feel more prepared and less anxious. These “gross” things are simply normal bodily functions happening during one of the most incredible events of your life. They are temporary, and your medical team is expertly equipped to handle them with professionalism and care.
Focus on the end goal: the immense joy of meeting your baby. Your body is powerful, capable, and amazing. Give yourself grace, trust your healthcare providers, and remember that you are doing something extraordinary. You’ve got this, mama.